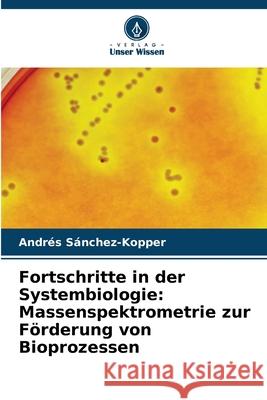
Fortschritte in der Systembiologie: Massenspektrometrie zur Förderung von Bioprozessen Sánchez-Kopper, Andrés 9786208906184 Verlag Unser Wissen - książka

Fortschritte in der Systembiologie: Massenspektrometrie zur Förderung von Bioprozessen » książka
Fortschritte in der Systembiologie: Massenspektrometrie zur Förderung von Bioprozessen
ISBN-13: 9786208906184 / Niemiecki / Miękka / 2025 / 176 str.
Fortschritte in der Systembiologie: Massenspektrometrie zur Förderung von Bioprozessen
ISBN-13: 9786208906184 / Niemiecki / Miękka / 2025 / 176 str.
(netto: 341,17 VAT: 5%)
Najniższa cena z 30 dni: 358,23
ok. 10-14 dni roboczych
Bez gwarancji dostawy przed świętami
Darmowa dostawa!
Die Systembiologie, die sich mit dem Verständnis und der Vorhersage der Funktionsweise der intrazellulären Maschinerie befasst, benötigt neue technologische Unterstützung, um den Zellstoffwechsel auf allen Ebenen beobachten zu können. Vom Genom des Organismus über seine Transkription bis hin zu den Proteinen und der Art und Weise, wie diese Proteine die Metabolitenpools als endgültige Reaktion auf bestimmte Stimuli regulieren, ist ein genauer Blick auf spezifische Stoffwechselzustände erforderlich. Die Massenspektrometrie wird eingesetzt, um intrazelluläre Informationen auf Metabolomics-, Peptidomics- und Proteomics-Ebene für spezifische Fragen zur Optimierung von Bioprozessen zu erhalten.